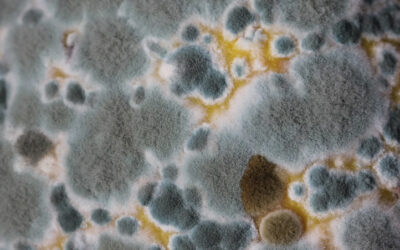

BLOG
Allergies in the Fall?
As the season moves from summer into fall in Sonoma County, many people notice they are coughing, getting sinusitis, or having other allergy symptoms.
Two Important Tips to Boost Your Immune System
Learn about two ways to boost your immune system during cold season.
Three Tests for a Sharper Mind
There are several issues that we assess when looking at low mental acuity.
Brain Fog, Memory Loss, Hair Loss, and Rashes on Face and Scalp
Chemical found in tap water causing a multitude of symptoms.
Toxin Causing Weight Gain and Blood Sugar Issues
Possibly avoid blood sugar medications and understand uncharacteristic weight gain.
Bacteria Causing Join Pain?
Lingering bacteria can migrate to your joints, causing on-going pain.
High Estrogen in Men
Low testosterone levels in men can cause many symptoms.
Low Estrogen Symptoms from an Environmental Chemical
Atrazine, a known chemical in weed killer pesticides, is causing low estrogen symptoms in women.
Lack of Emotional Control or Overreacting
An environmental toxin is causing emotional turmoil in some patients.
Cortisol Sensitivity
Your fatigue may because you have a sensitivity to cortisol.
Glyphosates Can Prevent Healing After Injury
After I injured my foot and knee, no amount of therapy was helping, until I learned about glyphosates.
New Toxins in Foods
A month ago I had a colleague test my water and food samples. I was astonished at the level of glyphosates in the water.
Resolving the Reasons for Fatigue in the Spring
In May and June, Sonoma County is a high pollen area so I ask all my patients if they have more fatigue or brain fog.
Resolving Headaches
Here we discuss the four different kinds of headaches for both men and women.
Two Little-Known Important Flu Tips for the Season
The traditional primary flu season is December thru February. During this time, viruses can be the primary cause of illness.
Allergy Relief in Sonoma County
Spring is here! With the heavy rains experienced this winter, the clinic is seeing an increase in the pollen levels.
Spring Fatigue
Resolving the reasons for fatigue in the Spring may leave you more energetic and with less brain fog
Managing Pollen Reactions
We are so fortunate to live in such a beautiful place. Unfortunately, for many people, spring is a time of suffering due to reactions to the pollen in the air.
How Mold Affects Your Nervous System and Body
Symptoms of mold and mold toxin exposure includes both mental and physical issues.
Resolving Cases of Hives and Other Skin Reactions
Over the years, we have helped many patients resolve their reactive skin issues.
Tired of Avoiding Food Sensitivities?
There are several therapies that our clinic has been using since 1995 in Sonoma County to help people overcome food reactions.
Improved Short and Long-Term Energy
After working with several patients with long COVID, I am checking everyone for short and long-term energy fatigue.
Help with Muscle Pain and Fatigue
Chronic pain and fatigue can be very stressful and frustrating, especially if it has been going on for a long time.
Common and Uncommon Symptoms of Pollen Allergies
We all know about common hay fever symptoms, but what about other uncommon symptoms?
Chronic Cough and Other Complications with Infections
Many people are now experiencing health symptoms after the infection of COVID—some patients for an extended period of time.
3 Reasons for Brain Fog (and Sometimes Low Motivation)
I have seen many patients where their brain fog has come and then resolved. One patient
4 Reasons for Stomach Issues
There are many reasons for stomach issues, and we are going to go over four of them.
Natural Relief from Poison Oak
Recently, several patients have come in with severe poison oak reactions. The clinic has worked with poison oak reactions for many years successfully.
Can Food Sensitivities cause Sinus Problems?
Watch this video to learn more about how food sensitivities may be causing you sinus issues.
Three Tips to Falling Asleep Naturally
Sleeping pills can be very addictive, so it is important to fall asleep naturally without medications. Here are 3 tips that may help you fall asleep naturally.
Foot and Hand Pain
In the last 2 years the clinic has treated many patients with foot and hand pain with great success. I check and treat several different factors when looking at feet and hand pain.
Bioidenticals – When Things Go Wrong
In the last blog, I discussed when the hormonal system is imbalanced by bioidentical hormones. In many women this does not happen.
Bioidentical Hormones – Friend or Foe
Are bioidentical hormones the best way to decrease your hormonal symptoms? Are there side-effects to these substances?
Stomach Issues & Other Digestive Problems
Many of my patients have recovered from digestive issues whether they are long term problems or short term issues.
Getting Relief from Sugar, Carb and Other Food Cravings
Over the past ten years many patients have come to the clinic with sugar and carbohydrate cravings. These cravings are common symptoms that present themselves.
Anxiety, Depression, and Hormones
When moving from the holistic health arena to the addiction treatment arena, I was shocked at how the addiction and dependency treatment centers do not look at hormonal imbalances…
Every Year “The Worst Pollen Year”
Each year for the last five years seems to be “the worst pollen year.”
“Pollenpocalypse”
Many have predicted a bad pollen season this year, some calling it “Pollenocalypse”! Here are five things the clinic can test to help.
Stomach Problems & Medications
Stomach acid reducers are among the top prescribed medication in the U.S. today. They can be very effective, however they are not designed to be used long term.
Anxiety – A Hormonal or Mental Health Issue?
This question refers to women with anxiety. A patient in her mid-forties came to the office with moodiness and anxiety.
Hormonal Component to a Holistic Wellness Alcohol Program
As a holistic wellness alcohol program in Sonoma County, our clin-ic looks at the hormonal component of cravings or addiction to al-cohol. Many factors influence our hormonal system and the bio-chemistry of cravings.
Digestive Issues: Heartburn, Gerd, Indigestion, Bloating
Heartburn, Gerd, Acid Stomach, Indigestion, Bloating – there are many names for problems with the digestive system. Most people have had problems at some point with their digestion.
Practical Help for the Holidays
Tis the season to be merry. But the hustle and bustle and emotional ups and downs sometime interfere with our ability to enjoy the holidays.
Smoke and Anxiety
This has been a challenging year after the fires. Here are some health issues that we are looking at for people after the fires.